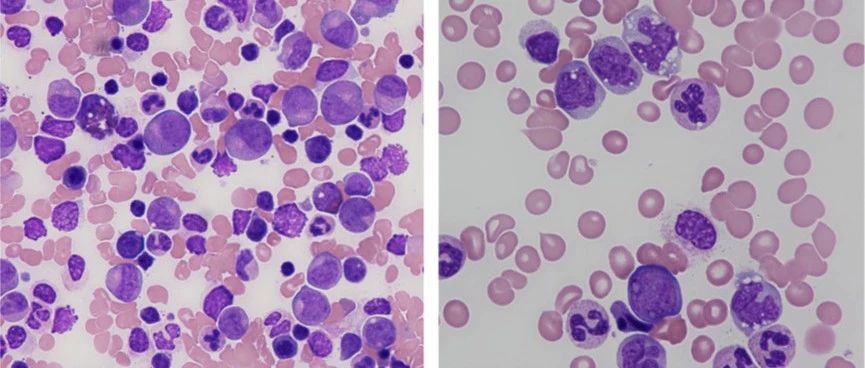

【临床病例(理)讨论】造血功能障碍继发非结核分枝杆菌感染及肺泡蛋白沉积症
作者:石穿 侯小萌 麦毓麟 留永健 罗金梅 李霁 冯瑞娥 施举红 王京岚 田欣伦 杨燕丽单位:中国医学科学院 北京协和医学院 北京协和医院内科;中国医学科学院 北京协和医学院 北京协和医院呼吸与危重症医学科;中国医学科学院 北京协和医学院 北京协和医院病理科引用本文: 石穿, 侯小萌, 麦毓麟, 等. 造血功能障碍继发非结核分枝杆菌感染及肺泡蛋白沉积症 [J] . 中华结核和呼吸杂志, 2023, 46(2) : 158-163. DOI: 10.3760/cma.j.cn112147-20220712-00594....